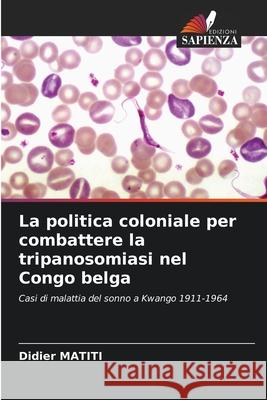
La politica coloniale per combattere la tripanosomiasi nel Congo belga MATITI, Didier 9786208708542
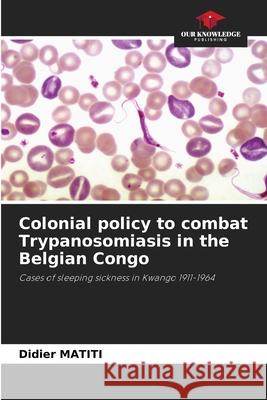
Colonial policy to combat Trypanosomiasis in the Belgian Congo MATITI, Didier 9786208708528

topmenu
Wyniki wyszukiwania:
wyszukanych pozycji: 6
 |
Kolonialna polityka zwalczania trypanosomatozy w Kongu Belgijskim
ISBN: 9786208708559 / Polski / Miękka / 2025 / 60 str. Termin realizacji zamówienia: ok. 10-14 dni roboczych. |
cena:
199,13 |
 |
Koloniale Politik zur Bekämpfung der Trypanosomiasis in Belgisch-Kongo
ISBN: 9786208708511 / Niemiecki / Miękka / 2025 / 52 str. Termin realizacji zamówienia: ok. 10-14 dni roboczych. Das Thema, das wir uns erlaubt haben zu untersuchen, lautet: "Koloniale Politik zur Bekämpfung der Schlafkrankheit. Der Fall des Kwango-Distrikts (1911-1964)". Dieses Thema hat uns gezeigt, wie wichtig die Auswirkungen der menschlichen Trypanosomiasis in der Welt und in unserem Land sind. Wir haben daher versucht, einen kleinen Beitrag zu den Problemen der Krankheit in unserem Land zu leisten.
Das Thema, das wir uns erlaubt haben zu untersuchen, lautet: "Koloniale Politik zur Bekämpfung der Schlafkrankheit. Der Fall des Kwango-Distrikts (19...
|
cena:
199,13 |
|
La politica coloniale per combattere la tripanosomiasi nel Congo belga
ISBN: 9786208708542 / Włoski / Miękka / 2025 / 60 str. Termin realizacji zamówienia: ok. 10-14 dni roboczych. |
cena:
199,13 |
 |
Política colonial de luta contra a tripanossomíase no Congo Belga
ISBN: 9786208708566 / Portugalski / Miękka / 2025 / 60 str. Termin realizacji zamówienia: ok. 10-14 dni roboczych. |
cena:
199,13 |
|
Colonial policy to combat Trypanosomiasis in the Belgian Congo
ISBN: 9786208708528 / Angielski / Miękka / 2025 / 60 str. Termin realizacji zamówienia: ok. 10-14 dni roboczych. The subject we have taken the liberty of studying is entitled: "Colonial policy to combat sleeping sickness. Cas du district de Kwango (1911-1964)". This subject has made us aware of the major impact of human trypanosomiasis, both worldwide and in our own country. We have therefore tried to make our small contribution to the problems of disease in our country.
The subject we have taken the liberty of studying is entitled: "Colonial policy to combat sleeping sickness. Cas du district de Kwango (1911-1964)". T...
|
cena:
199,13 |
 |
Politique coloniale de lutte contre la Trypanosomiase au Congo belge
ISBN: 9786206731597 / Francuski Termin realizacji zamówienia: ok. 10-14 dni roboczych. |
cena:
199,13 |










